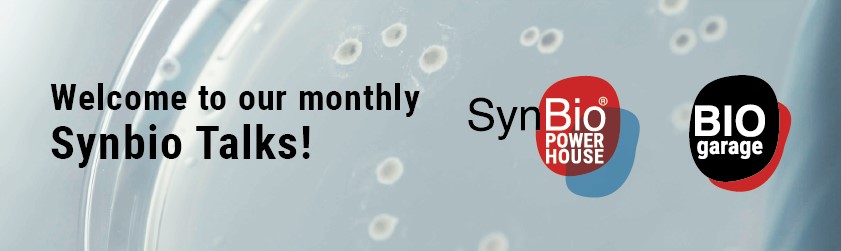

Invitation by Lantmännen in co-operation with Urban Mill:
How can we challenge the way we produce and eat food to resolve two of the world’s most urgent problems: climate change and increasing health issues?

We are facing major challenges, both in terms of the way we produce food and how we consume it. Our planet must feed a growing population, and at the same time sustainability challenges and health problems related to the food we put on our plates are increasing globally. A development that we at Lantmännen are convinced that we can change. Together.
Do you have fresh insight on sustainable nutrition to complement our expertise? An excellent idea for a new plant-based product? An unexplored solution for using manufacturing process sidestreams adding value to more healthier products? Maybe a business model to change consumer behavior towards more sustainable way? Or maybe a breakthrough insight for oat or wholegrain?
Take the chance and apply to the Greenhouse now! Application period ends 31st of March 2021.
More information: http://www.lantmannen.com/research-and-innovation/The-greenhouse/